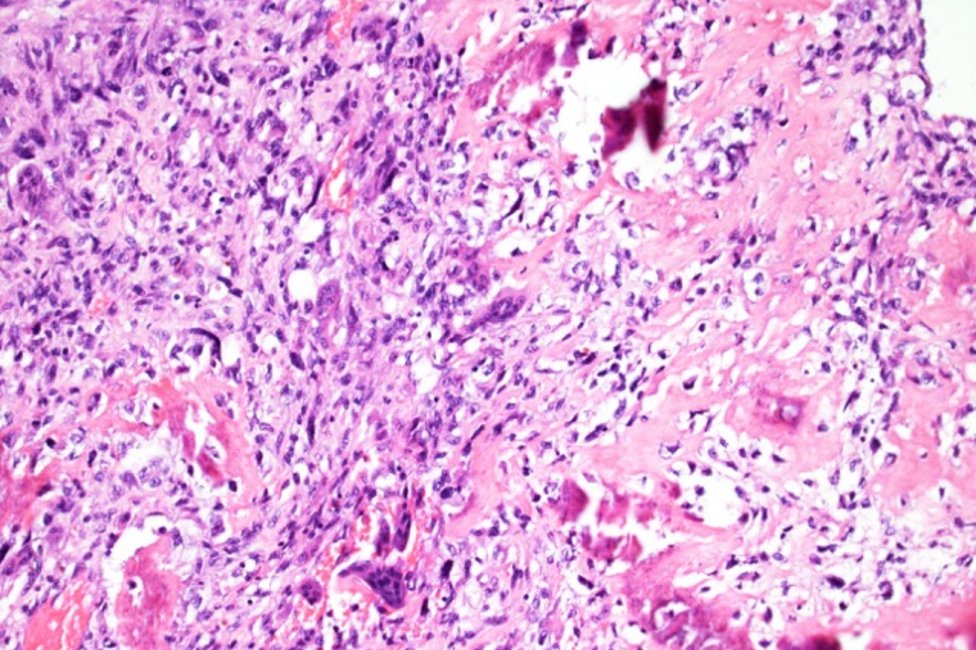

Frau Prof.in Salzer-Kuntschnik hat sich ab 1962 intensiv mit Knochenläsionen beschäftigt und diese auch völlig neu klassifiziert, da in enger Zusammenarbeit mit der Abteilung für Tumororthopädie der Universitätsklinik für Orthopädie eine exakte Klassifizierung der Tumoren aus diesem Bereich dringlich erforderlich war. Gleichzeitig konnte durch die Vielzahl an verschiedenen Entitäten des Skelett- und Weichteilgewebes 1962 das Wiener Knochentumorregister gegründet und aufgebaut werden, welches die Basis für die wissenschaftliche Arbeit an diesen Tumoren darstellt.
In diesem Zusammenhang wurde das Orthopädische-Pathologische Labor am Institut für Pathologie etabliert. In weiterer Folge wurden auch die Universitätsklinik für Mund-, Kiefer- und Gesichtschirurgie sowie die Zahnklinik als Einsender dem Labor zugeteilt, da diese Bereiche bzw. der Kieferknochen ebenso eine spezielle Bearbeitung benötigen. Das Labor ist somit spezialisiert auf die technische Verarbeitung von Knochengewebe mit den entsprechenden Großgeräten wie Sägen und Spezialmikrotomen. Es werden verschiedene Entkalkungsmethoden sowie auch die Verarbeitung mittels Harteinbettung angeboten. Auch eine eigene Gefrierschnitteinheit ist für die Tumororthopädie aufgestellt. Die Laboreinheit erzeugt jährlich ca. 50.000 histologische Gewebsschnitte, die von fünf Patholog:innen nach den neuesten Erkenntnissen beurteilt werden.
Leitung
Ass.-Prof.in Dr.in Susanna LANG
E-Mail: susanna.lang@meduniwien.ac.at
Stellvertretung Leitung
Ao. Univ.-Prof.in Dr.in Irene SULZBACHER
Wir ersuchen um Verständnis, dass wir Kooperationen auf Grund des hohen Volumens von Anfragen nicht in allen Fällen und nur nach vorheriger Kontaktaufnahme mit der:dem Leiter:in (per E-Mail) der Arbeitsgruppe in der Planungsphase eines Projektes und bei wissenschaftlichem Interesse eingehen können.